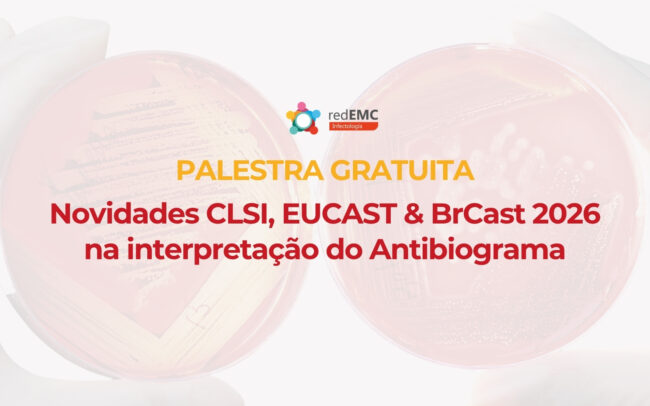

All
Cursos de Infectologia
Evimed e a Rede de Educação Médica Continuada para América Latina, RedEMC, apresenta seus cursos 2020 sobre infectologia. Os mesmos são ditados de maneira 100% on-line. Isto permite a participação de qualquer lugar do mundo e em qualquer momento.
Os cursos estão direcionados a infectologistas, especialistas em doenças infecciosas, microbiologistas, bioquímicos, laboratoristas, farmacêuticos clínicos, residentes e outros profissionais da saúde interessados na temática.
A inscrição se realiza através do formulário de pagamento de cada curso, onde você encontrará também as formas de fazê-lo: cartão de crédito ou débito e boleto bancário. Para obter mais informações sobre os cursos, escreva a cursos@evimed.net ou acesse página do curso que quiser realizar.